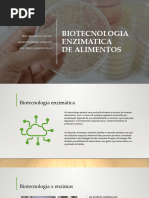

100% acharam este documento útil (1 voto)
471 visualizações45 páginasClassificação - Frutas
Descrição e classificação das principais frutíferas utilizadas em tecnologia e processamento na industria de alimentos.
Enviado por
Adriana Cibele Mesquita DantasDireitos autorais
© © All Rights Reserved
Levamos muito a sério os direitos de conteúdo. Se você suspeita que este conteúdo é seu, reivindique-o aqui.
Formatos disponíveis
Baixe no formato PDF, TXT ou leia on-line no Scribd
100% acharam este documento útil (1 voto)
471 visualizações45 páginasClassificação - Frutas
Descrição e classificação das principais frutíferas utilizadas em tecnologia e processamento na industria de alimentos.
Enviado por
Adriana Cibele Mesquita DantasDireitos autorais
© © All Rights Reserved
Levamos muito a sério os direitos de conteúdo. Se você suspeita que este conteúdo é seu, reivindique-o aqui.
Formatos disponíveis
Baixe no formato PDF, TXT ou leia on-line no Scribd